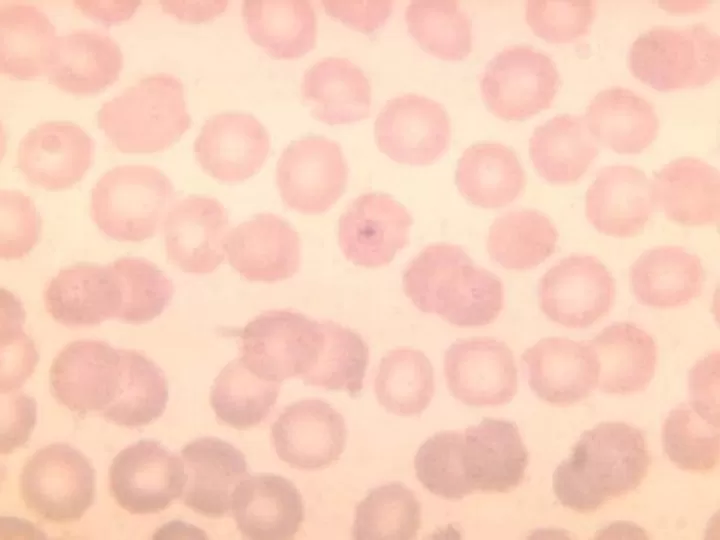
delicatos

Explora la deliciosa variedad de Delicatos y su Dulce de Coco en 6 pack
Prueba estos deliciosos bollos de chocolate y coco. Su textura suave y esponjosa junto a su sabor característico te harán disfrutar cada bocado. Además, no contienen conservantes ya que están horneados.
SeProductos recomendados por compradores frecuentes
¡Bienvenido a nuestra tienda en línea!
Para que puedas disfrutar de una experiencia de compra óptima, es necesario que aceptes el uso de cookies. Estos pequeños archivos son esenciales para garantizar el rendimiento de nuestro sitio web, así como para ofrecerte contenido personalizado en redes sociales y publicidad.
Las cookies de redes sociales y de terceros nos permiten brindarte funciones sociales y anuncios adaptados a tus intereses. De esta manera, podrás compartir fácilmente tus productos favoritos con tus amigos y familiares, además de recibir recomendaciones personalizadas en nuestra tienda.
¿Estás de acuerdo en aceptar estas cookies y el procesamiento de tus datos personales asociados?
Tu privacidad es importante para nosotros, por lo que puedes estar seguro de que trataremos tus datos con total confidencialidad y cumpliendo todas las normativas vigentes. Si deseas obtener más información sobre nuestra política de cookies y privacidad, puedes consultar nuestros términos y condiciones.
Agradecemos tu elección de confiar en nosotros y esperamos que disfrutes de una experiencia de compra única en nuestra tienda.
Introducción a los deliciosos bollos de chocolate y coco
Los bollos de chocolate y coco son uno de los postres más populares y deliciosos en todo el mundo. Esta combinación perfecta de sabores dulces y texturas suaves los convierten en un verdadero placer para el paladar.
El chocolate es un ingrediente clave en estos bollos, ya que su sabor intenso y suave textura se combinan a la perfección con el coco, creando una armonía de sabores en cada mordisco.
Además de su delicioso sabor, estos bollos también tienen beneficios nutricionales. El chocolate es rico en antioxidantes y el coco es una fuente de grasas saludables, lo que los convierte en un postre indulgente pero nutritivo.
Existen muchas variaciones y recetas de bollos de chocolate y coco, pero todos comparten la misma base de ingredientes. La masa suave y esponjosa, el dulce relleno de chocolate y la capa crujiente de coco rallado en la parte superior hacen de estos bollos una verdadera obra maestra de la repostería.
Ya sea para un desayuno especial, una merienda o simplemente para darse un capricho, estos bollos nunca decepcionan y siempre dejan un delicioso sabor de boca.
¡Así que no lo pienses más y prueba estos exquisitos bollos de chocolate y coco, te aseguramos que te encantarán!
Cómo preparar unos bollos de chocolate y coco suaves y esponjosos
Si eres amante del chocolate y del coco, estás de suerte, porque hoy te traemos la receta perfecta para saciar tus antojos. Se trata de unos deliciosos bollos de chocolate y coco, que además son suaves y esponjosos. ¿Listo para aprender a prepararlos?
Para hacer estos bollos necesitarás:
Comienza mezclando la harina, el azúcar, el coco rallado, la levadura y la sal en un bol grande. Añade también el chocolate troceado y mezcla bien.
En otro bol, bate los huevos y añade la leche y la mantequilla derretida. Une esta mezcla a la anterior y amasa bien hasta que obtengas una masa uniforme y suave.
Forma bolas con la masa y colócalas en una bandeja de horno previamente engrasada. Deja que reposen durante media hora para que leude la masa.
Transcurrido el tiempo de reposo, precalienta el horno a 180 grados y hornea los bollos durante 15-20 minutos, o hasta que estén dorados.
Una vez listos, saca los bollos del horno y déjalos enfriar antes de servir. ¡Y listo! Ya tienes unos deliciosos bollos de chocolate y coco suaves y esponjosos para disfrutar solo o acompañados de un buen café o té.
Esperamos que te haya gustado esta receta y que la pongas en práctica en casa. ¡No te arrepentirás!
Los ingredientes clave para lograr el sabor perfecto
En la búsqueda constante del sabor perfecto, es común encontrarnos con una gran cantidad de ingredientes y técnicas culinarias que prometen llevar nuestros platillos al siguiente nivel. Sin embargo, existen algunos ingredientes clave que no pueden faltar en la cocina de todo buen chef.
1. Especias y hierbas
Las especias y hierbas son esenciales para darle ese toque de sabor único a nuestros platillos. Ya sea en forma de sazonador, en polvo o frescas, estas pequeñas y poderosas adiciones pueden transformar por completo el sabor de cualquier comida. Algunas de las más utilizadas son: orégano, romero, comino, ajo en polvo y pimentón.
2. Salsa de soja
La salsa de soja, también conocida como salsa de soya, es un ingrediente secreto para muchos chefs profesionales gracias a su alto contenido de umami, el quinto sabor básico. Esta salsa aporta un sabor salado y ahumado a los platillos, dándoles una profundidad única en el paladar.
3. Caldo de pollo
El caldo de pollo es un ingrediente básico en cualquier cocina. Además de ser utilizado como base para sopas, guisos y arroces, también es una excelente opción para darle más sabor a nuestros platillos. Utilízalo para cocinar carnes, verduras o incluso para reemplazar el agua en algún guiso, y verás cómo el sabor de tus platillos se eleva.
Con estos tres ingredientes clave en tu cocina, podrás darle el toque perfecto a tus platillos y sorprender a tus comensales con sabores deliciosos e inolvidables. Recuerda siempre experimentar con diferentes combinaciones y cantidades para encontrar tu propia receta del sabor perfecto.
Paso a paso: el arte de hornear los bollos
Los bollos son un delicioso y versátil pan que se puede disfrutar en cualquier momento del día. Desde un desayuno con café hasta como acompañamiento de una cena, los bollos son siempre una buena elección.
Si eres un amante de la cocina y quieres aprender el arte de hornear los bollos, estás en el lugar adecuado. Aquí te dejamos una sencilla receta y los pasos a seguir para que puedas hacer tus propios bollos caseros.
Ingredientes:
Paso 1: Preparación de la masa
En un recipiente, mezcla la harina, la levadura, la leche tibia y el azúcar. Amasa todos los ingredientes hasta obtener una masa homogénea. Agrega el huevo, la sal, la mantequilla y la esencia de vainilla. Continúa amasando hasta que la masa se despegue de las manos.
Paso 2: Reposo de la masa
Cubre la masa con un paño y déjala reposar en un lugar cálido durante 1 hora. De esta forma, la masa crecerá y se volverá más esponjosa.
Paso 3: Dar forma a los bollos
Divide la masa en 8 o 10 porciones y dales forma redonda. Colócalas en una bandeja de hornear previamente engrasada.
Paso 4: Hornear los bollos
Con el horno precalentado a 180°C, coloca la bandeja con los bollos y hornéalos durante 20 minutos o hasta que estén dorados.
Paso 5: Disfrutar los bollos
Una vez listos, retira los bollos del horno y déjalos enfriar por unos minutos. Servir tibios y acompañados de tu relleno favorito, ya sea mermelada, mantequilla o queso crema.
Ahora que ya conoces el paso a paso para hornear los bollos, no dudes en poner en práctica esta receta en tu cocina y sorprender a tu familia y amigos con unos deliciosos bollos caseros.








